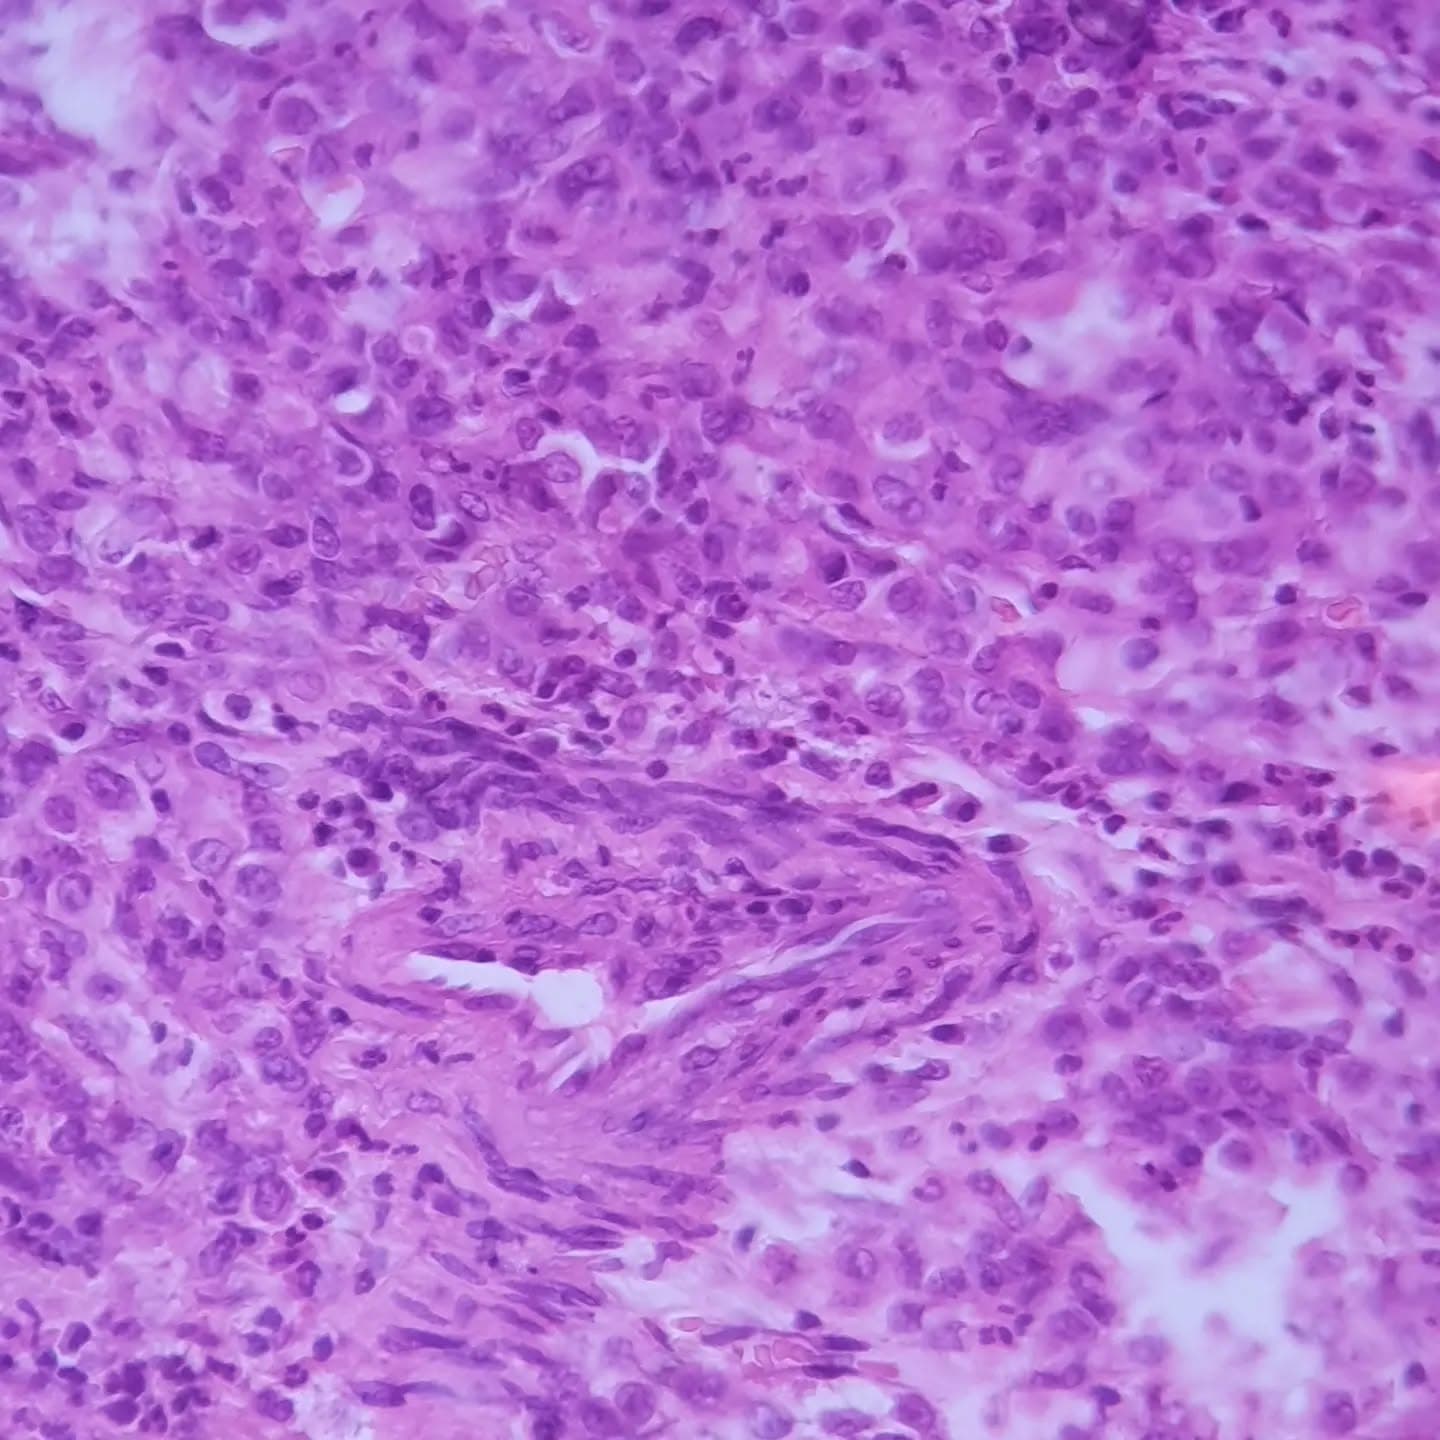
Terrifying poorly differentiated gastric adenocarcinoma with signet ring features.. Marked pleomorphism of tumor cells with many atypical mitotic figures,
forming glands in a small foci (slide 4), invading through muscularis propria layer and beyond (slide 9)
and its cruel lymphovascular invasion
(slide 10: a lonely vessel surrounded by attacking malignant cells)

Back to Posts
July 14, 2022
Photo 1 of 10
professionalterrifyingpoorly
Caption: Terrifying poorly differentiated gastric adenocarcinoma with signet ring features.. Marked pleomorphism of tumor cells with many atypical mitotic figures, forming glands in a small foci (slide 4), invading through muscularis propria layer and beyond (slide 9) and its cruel lymphovascular invasion (slide 10: a lonely vessel surrounded by attacking malignant cells)